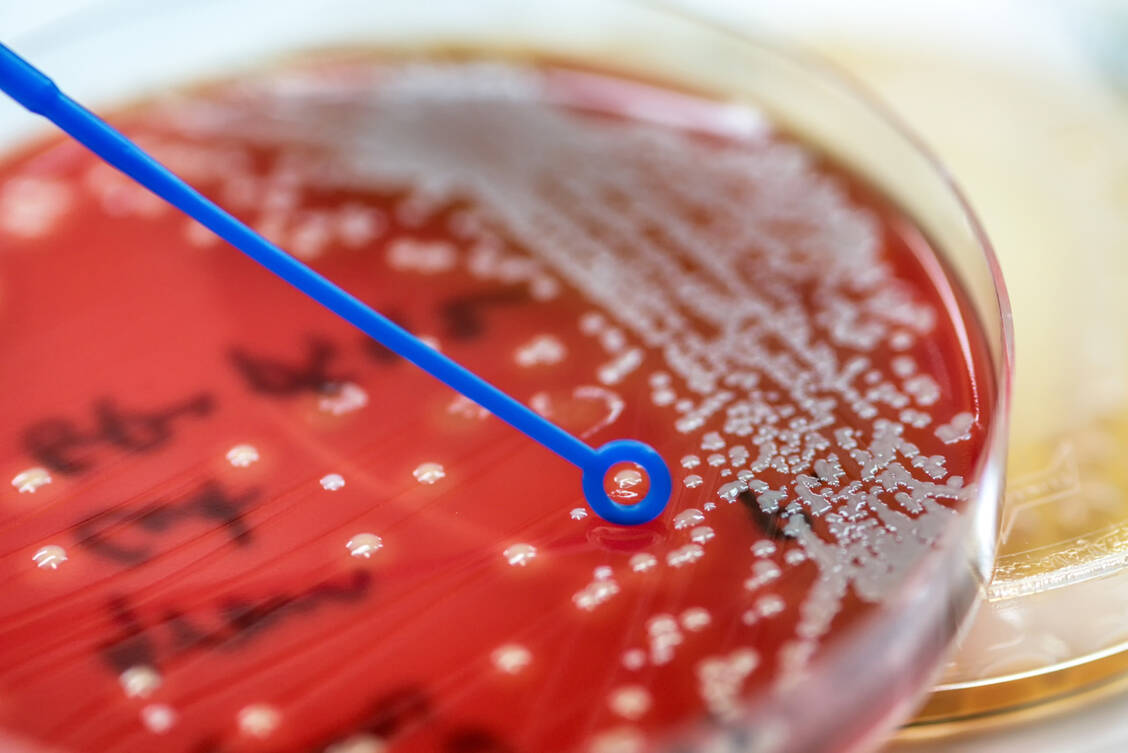
Antibiotikaresistenzen sind eine globale Gesundheitsbedrohung. Die Therapiemöglichkeiten bei Mensch und Tier werden dadurch stark eingeschränkt. / © Adobe Stock/analysis121980

Hier gilt es, durch die Beobachtung von Wetterlagen und Pollenkonzentrationen eine präzisere Frühwarnung für Allergiker zu entwickeln, als herkömmliche Pollenkalender sie bieten. Traidl-Hoffmann: »Ein Frühwarnsystem für Allergiker etwa bezüglich solcher Wetterlagen wäre ein gutes Instrument, um Klimaresilienz aufzubauen. Das Klima und die Folgen seiner Veränderung verhalten sich für den Menschen nicht linear. Natürliche Resilienz schützt und federt Veränderungen ab, eben bis zu einem Punkt, an dem das System kippt. Den Klimawandel aufhalten können wir nicht, wir können ihn nur abmildern, indem wir versuchen, eine Klimaresilienz aufzubauen, also Strategien zu entwickeln, wie wir trotzdem überleben können.«